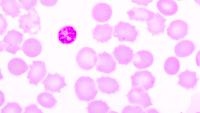
red blood cells infected with malaria parasite

Transforming Human Health
Driving discovery, advancing care, and educating leaders

Our Schools
Advancing Care
News
Our Community

Learn more about our role in serving the Northern Manhattan community of Washington Heights, Inwood, and Harlem.
Inclusion & Belonging

At CUIMC, we are committed to providing culturally inclusive medical education, research, and clinical care.